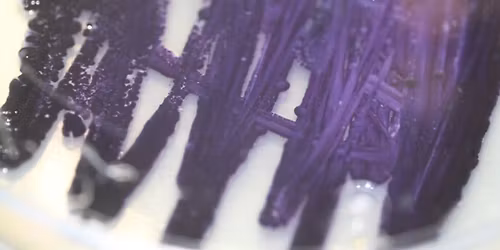
PhD defence: Co-Cultivating Colours

Indendørs loppemarked Harte fritidscenter
Schedule
Sun Nov 02 2025 at 10:00 am to 02:00 pm
UTC+01:00Location
Stupdrupvej 44, 6000 Kolding, Denmark | Kolding, VJ
Advertisement
96 stande. SAMTLIGE STANDE ER BOOKET. Gratis entré
Dørene åbnes for køberne kl.10.
Det vil være muligt at købe mad og drikkevarer i klubbens madbod.
Indtægten fra salg af stande og overskuddet fra salget i madboden går til Harte G&IF
Advertisement
Where is it happening?
Stupdrupvej 44, 6000 Kolding, Denmark, Stubdrupvej 44, 6000 Kolding, Danmark, Kolding, DenmarkEvent Location & Nearby Stays:
Know what’s Happening Next — before everyone else does.